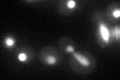
YGL043W
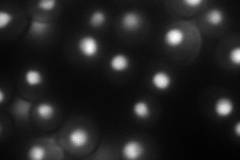
YGL043W
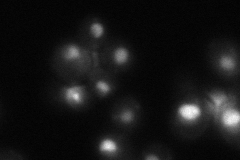
YGL043W

View description
General transcription elongation factor TFIIS, enables RNA polymerase II to read through blocks to elongation by stimulating cleavage of nascent transcripts stalled at transcription arrest sites
Localization:
Intensity:
Fold change:
Significance:
-
C’ GFP library in SD
nucleus53.96 -
N' NOP1pr-GFP in SD
nucleus126.324 -
N' TEF2pr-mCherry in SD

nucleus185.533 -
N' NATIVEpr-GFP in SD
nucleus34.6524 -
N' TEF2pr-VC and Cyto-VN in SD

#N/A0 -
C’ GFP library in SD+DTT

nucleus46.470.86No -
C’ GFP library in SD+H2O2

nucleus44.050.81No -
C’ GFP library in Starvation Media

nucleus39.970.74No -
C’ GFP library on the background of Pup2-DaMP

nucleus -
C’ GFP library on the background of CCT mutant

nucleus78.1471.44799Yes
